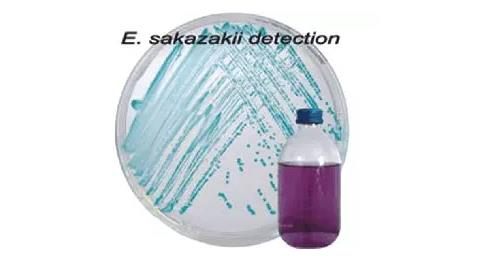

板岐肠杆菌可致婴儿死亡,为何只有1段奶粉不得检出?
1、板岐肠杆菌生命力强,广泛存在,对新生儿、早产儿、低出生体重婴儿有较大威胁。
2、婴儿配方奶粉和辅食常有板岐肠杆菌检出,但国家标准及主要发达经济体重点控制1段奶粉。
3、保持家庭环境卫生,定期消毒奶瓶、奶嘴,用70度以上的热水冲调奶粉是最好的预防方式。
这是个什么细菌?怎么平时没怎么听说呢?
阪崎肠杆菌常生活在人和动物的肠道,它于上世纪80年代才被发现,2006年重新命名为阪崎克罗诺肠杆菌,对科学界而言确实是一种相对比较新的细菌。

【生命力顽强】
阪崎肠杆菌的生命力非常顽强,它耐寒、耐热、耐干燥、耐酸碱、耐渗透压、耐紫外线,对消毒杀菌剂也有比较强的抵抗力。
它在遇到不利条件的时候,会迅速分泌多糖成分将自己包裹起来,这些多糖不仅可以保护它还具有粘附性,所以一旦污染食品生产线,十分难以去除。
阪崎肠杆菌体内可以产生海藻糖,保护其生物大分子的活性,因此它可以在非常干燥的环境里(比如婴儿配方粉)存活2年之久,且能承受58-68度的温度。
【专攻小孩】
阪崎肠杆菌属于“条件致病菌”,它对有的人来说杀伤力巨大,对有的人却似乎毫无影响。
其主要攻击目标是婴幼儿和老人,但最常见于新生儿、早产儿、出生体重低下或免疫力低下的婴儿。
较大的婴儿和成年人有肠道菌群的保护,通常不容易受到阪崎肠杆菌的袭击。
阪崎肠杆菌除了可引起腹泻、发烧,还可引起十分严重的感染症状,例如脑膜炎、菌血症和坏死性小肠结肠炎,总体感染死亡率可达到20-50%。
它是新生儿脑膜炎常见的病因,且治愈后也常留有神经系统后遗症。
不过它也没有那么可怕,根据美国的数据,1岁以下婴儿的感染率只有十万分之一,低体重新生儿感染率为十万分之8.7。
当然,科学界对这种细菌的了解还比较少,不像大肠杆菌、沙门氏菌,很多医院也没有将它作为常规检测项目,因此可能存在不少误诊、漏诊的情况。

【重点在婴配】
阪崎肠杆菌分布广泛,自然环境和厂房环境中常有它的存在,因此可以在很多食品中出现,例如蔬菜、水果、肉制品、谷物制品等。
根据以往不同调查中的数据,蔬菜、冰激凌、饼干、巧克力、坚果等污染率均超过10%。
除了厂房和环境的污染,食品原料也是阪崎肠杆菌常见的污染来源,例如面粉、果葡糖浆等。
不过由于它的攻击目标主要是婴儿,所以婴儿食品才是关注的重点。

婴儿配方粉中检出阪崎肠杆菌的情况还是比较少的,但婴幼儿辅食中污染阪崎肠杆菌较常见,从历年数据看,普遍达到10-30%。
比如佛山市检测60份婴幼儿食品,其中8份检出阪崎肠杆菌,全部是辅食类。
上海市松江区检测50余个谷类辅食,其中11个检出阪崎肠杆菌,而同批检测的50余个婴儿配方粉均未检出。
不过全球范围内近几十年的数据显示,婴儿感染阪崎肠杆菌的来源几乎全部是婴儿配方粉。

综合考虑阪崎肠杆菌的污染状况和风险特征,目前中国的国家标准(GB10765-2010)要求,0-6个月的婴儿配方粉(一段)不得检出阪崎肠杆菌,进口的一段奶粉也执行同样要求,但二段以上的婴儿配方粉和辅食(一般是半岁以后添加辅食)没有这个要求。
当然,考虑到很多生产线是同时生产不同段位的配方粉,所以其实是都有控制的。
国际标准和欧美发达国家的标准与此基本类似。

【如何防范风险】
对于一般的婴儿,阪崎肠杆菌和其他致病菌相比并没有特别的威胁,只需要注意保持家庭环境的清洁卫生即可。
比如曾经有不足一岁的孩子反复腹泻入院,治好了回去又复发,最后疾控中心的专家上门排查,发现奶瓶、奶粉勺、桌面均受到阪崎肠杆菌污染。
因此建议爸爸妈妈们冲奶前认真洗手,奶瓶、奶嘴、奶勺、奶瓶刷等器具定期消毒。

对于半岁以下的婴儿,尤其是无母乳喂养的新生儿、早产儿、低体重婴儿等,一定要注意冲奶粉的水的温度。
世界卫生组织推荐用70度以上的热水冲调奶粉,这个温度下几乎没有致病菌存活的机会。
有些婴儿配方粉的标签上建议用40多度的水来冲调,可能是考虑到对热敏感的营养素或益生菌。
但保险起见,对这些特别脆弱的婴儿,建议还是用热一点的水来冲奶。
此外,奶是很好的细菌培养基,因此没喝完的或不想马上喂给孩子的奶需要尽快放入冰箱,防止细菌繁殖,再喝之前还要充分加热。
